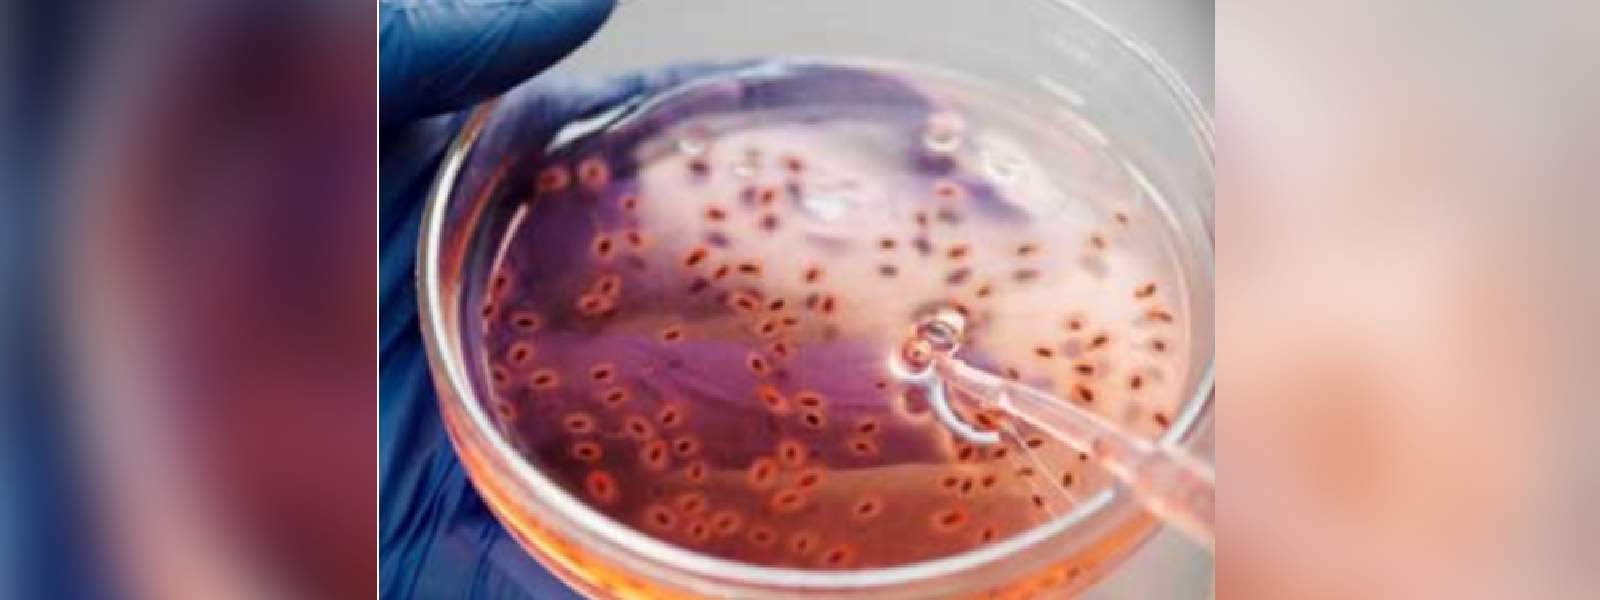
පාංශු උණ ගැන බොහෝ දෙනෙකු දැනුවත් නෑ..

.webp)
COLOMBO (News 1st) – ගොවීන් අතර මේ දිනවල පැතිර යන පාංශු උණ සම්බන්යෙන් බොහෝ දෙනෙකු දැනුවත්වී නැතැයි හිටපු කෘෂිකර්ම අධ්යක්ෂ කේ.බී ගුණරත්න මහතා පවසයි.
ඔහු පැවසුවේ, පසෙන් හා ජලයෙන් මෙම රෝගය පැතිර යන බවට සෞඛ්ය අංශ දන්වා ඇති බවයි.
පැතිර යන බව පැවසෙන මෙම රෝගය සම්බන්ධයෙන් ගොවිජනතාව විශේෂ අවදානයක් යොමු කළ යුතුව ඇතැයිද ඔහු සඳහන් කළේ ය.
මෙම රෝගය පාදයේ පවතින තුවාල මගින්, අපිරිසිදු ජලය පානය කිරීමෙන් සහ ආඝ්රාණය මගින් බැක්ටීරියාවක් ශරීරගත වී වැළදෙන බව සෞඛ්ය අංශ සඳහන් කළේ ය.
